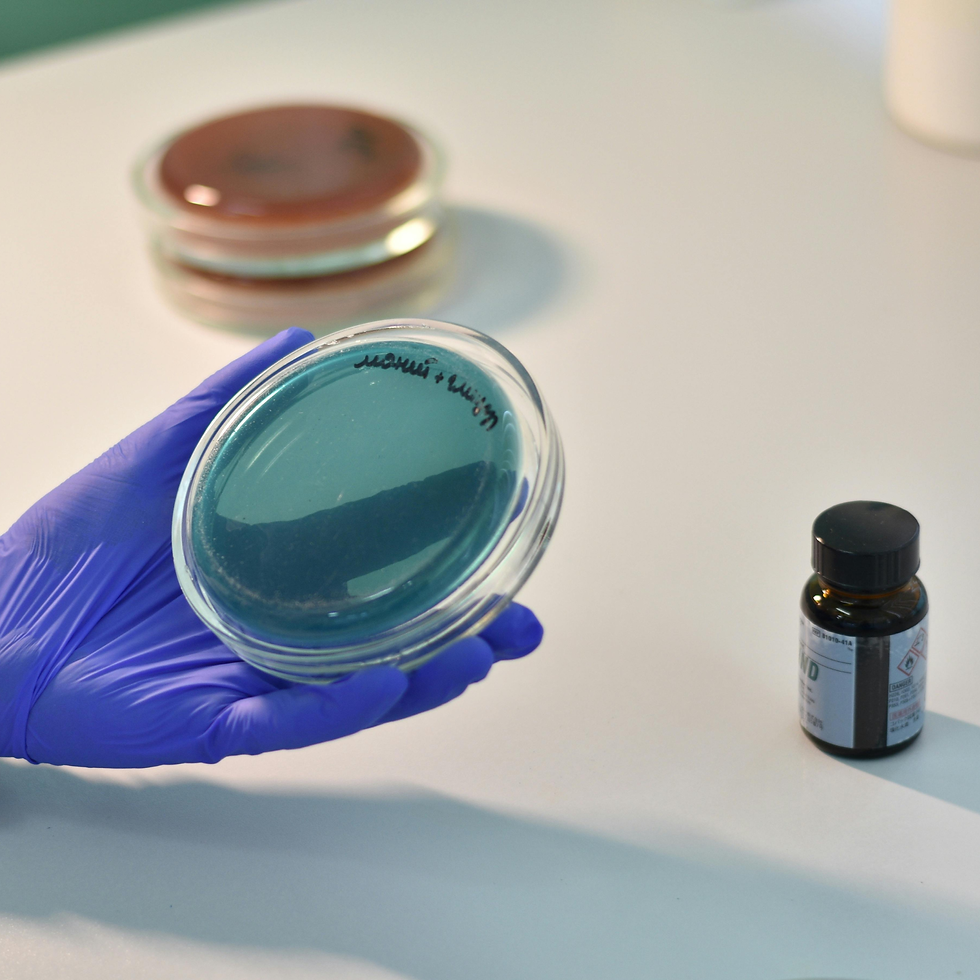
Micro Analysis

Micro
-
Total Viable Count
-
Yeast
-
Mould
-
Enterobacterae
-
E. Coli
-
Salmonella
-
Staphylococcus aureus
-
Bacillus cereus
Heavy Metals
-
Lead
-
Mercury
-
Cadmium
Lab Analysis.
Laboratory analysis is an important tool for verifying quality and protecting consumer safety. Independent testing provides objective confirmation that materials meet expected standards before they are used or released.
We work with UKAS accredited external laboratories to carry out microbiological and heavy metal testing on incoming raw materials when requested. Using independent facilities ensures transparency and removes any doubt around the integrity of results.
Upon request, finished products are analysed before release, offering additional reassurance that capsules meet safety expectations and agreed specifications. This testing is particularly valuable for brands prioritising consumer trust and long-term product integrity.


Micro
-
Total Viable Count
-
Yeast
-
Mould
-
Enterobacterae
-
E. Coli
-
Salmonella
-
Staphylococcus aureus
-
Bacillus cereus
Heavy Metals
-
Lead
-
Mercury
-
Cadmium
Micro
-
Total Viable Count
-
Yeast
-
Mould
-
Enterobacterae
-
E. Coli
-
Salmonella
-
Staphylococcus aureus
-
Bacillus cereus
Heavy Metals
-
Lead
-
Mercury
-
Cadmium
This page outlines our core service capabilities. We recognise that no two products are the same and therefore offer bespoke, customised solutions to meet unique formulation, sourcing, analytical, packaging, or production requirements. Please contact our team to discuss your product in detail and explore how we can deliver a tailored, end-to-end solution.